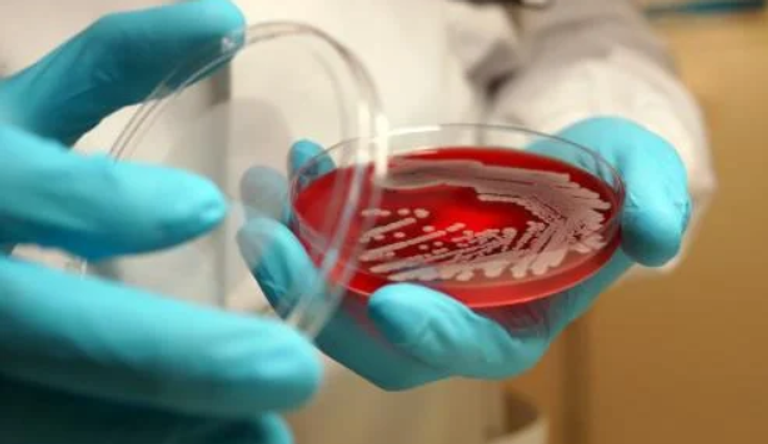
دعوات لوقف أبحاث الميكروبات المرآوية

«الميكروبات المرآوية» تهدد البشرية.. دعوات لوقف الأبحاث خوفا من عدوى مميتة
حذر علماء بارزون من خطر غير مسبوق قد تسببه الكائنات الدقيقة المصممة على شكل "حياة مرآوية"، ودعوا إلى تعليق البحث في هذا المجال بسبب المخاوف من أن هذه الكائنات الاصطناعية قد تشكل تهديدا كبيرا للحياة على كوكب الأرض.
وأبدت المجموعة الدولية من الحائزين على جائزة نوبل والخبراء في هذا المجال قلقهم من أن البكتيريا المرآوية، المصنوعة من صور عكسية للجزيئات الطبيعية الموجودة في الحياة، قد تستقر في البيئة وتتمكن من تجاوز الدفاعات المناعية للكائنات الطبيعية، مما يعرض البشر والحيوانات والنباتات لخطر الإصابة بالعدوى المميتة.
ما هي "الميكروبات المرآوية"؟
والميكروبات المرآوية هي كائنات دقيقة مصنوعة من جزيئات تعكس الجزيئات الطبيعية التي نجدها في الكائنات الحية.
مثلًا، الحمض النووي في الكائنات الحية يتكون من "نوكليوتيدات يمنى"، بينما البروتينات المصنوعة من الأحماض الأمينية تُبنى باستخدام "أحماض أمينية يسرى".
وتشير هذه الظاهرة إلى أن الحياة يمكن أن توجد في شكلين متناقضين، ولكن الحياة على الأرض اختارت استخدام الشكل "اليمنى" للحمض النووي و"اليسرى" للأحماض الأمينية.
وقد أجريت دراسات على هذه الجزيئات المرآوية المصنعة، وبعض العلماء بدأوا في خطوات أولية نحو بناء ميكروبات مرآوية، لكن إنشاء كائن حي كامل باستخدام الجزيئات المرآوية يتطلب معرفة متقدمة لم تتوفر بعد.

البحث والتطبيقات المستقبلية
وتحفز هذه الأبحاث الفضول والاهتمام بسبب الفوائد المحتملة، مثل استخدام الجزيئات المرآوية في علاج الأمراض المزمنة والصعبة العلاج، كما أن الكائنات الدقيقة المرآوية قد تساهم في جعل مرافق الإنتاج البيولوجي أكثر مقاومة للتلوث.
لكن التحذيرات الحالية تركز على المخاطر المحتملة لهذه الميكروبات، بما في ذلك احتمال عدم قدرة أنظمة المناعة في الكائنات الطبيعية على التعرف عليها أو مقاومة العدوى التي قد تنجم عنها، علاوة على ذلك، فإن استخدام المضادات الحيوية الحالية قد لا يكون فعالا ضد هذه الكائنات الجديدة.
دعوة للتوقف عن البحث
وفي تقرير مكون من 299 صفحة وتعليق نشر في مجلة "ساينس"، أشار العلماء إلى أن "الميكروبات المرآوية" قد تشكل خطرا غير قابل للتحكم.
ويعتقد الخبراء أن هذه الكائنات قد تتسبب في عدوى مميتة تنتشر بدون رادع، وأنه من غير المرجح أن تكون قابلة للحد من تأثيراتها من خلال التدابير البيولوجية الحالية.
وتشير المجموعة إلى أنه "ما لم يظهر دليل قاطع على أن الحياة المرآوية لن تشكل خطرا غير عادي، فإننا نعتقد أنه يجب عدم إنشاء البكتيريا المرآوية والكائنات المرآوية الأخرى، حتى تلك التي تحتوي على تدابير احتواء بيولوجي مهندسة".
إيقاف البحث هو الحل
ودعت هذه المجموعة العلماء إلى التوقف عن البحث في هذا المجال، وطالبت الجهات الممولة بإيقاف دعم هذه الأبحاث في المستقبل.
وقالت الدكتورة كيت آدمالا، عالمة الأحياء الاصطناعية بجامعة مينيسوتا ومؤلفة التقرير، "يجب ألا نصنع الحياة المرآوية، وهذا هو ما أردنا أن نؤكد عليه في هذا التقرير، والدعوة لبدء حوار عالمي حول الموضوع".
وفي تعليقه على التقرير، أشار البروفيسور بول فريمونت من كلية إمبريال بلندن إلى ضرورة إيجاد توازن بين مناقشة المخاطر والفرص المحتملة لاستخدام الكيمياء المرآوية في الأنظمة البيولوجية في المستقبل.
aXA6IDIxNi43My4yMTYuMTU0IA== جزيرة ام اند امز